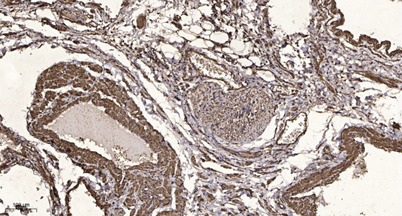

$148.00/50µL $248.00/100µL
| 50 µL | $148.00 |
| 100 µL | $248.00 |
| Product name: | SLC10A7 rabbit pAb |
| Reactivity: | Human;Mouse;Rat |
| Alternative Names: | SLC10A7; C4orf13; P7; PSEC0051; Sodium/bile acid cotransporter 7; Na(+)/bile acid cotransporter 7; Solute carrier family 10 member 7 |
| Source: | Rabbit |
| Dilutions: | WB 1:500-2000;IHC-p 1:50-300; ELISA 2000-20000 |
| Immunogen: | The antiserum was produced against synthesized peptide derived from human SLC10A7. AA range:168-217 |
| Storage: | -20°C/1 year |
| Clonality: | Polyclonal |
| Isotype: | IgG |
| Concentration: | 1 mg/ml |
| Observed Band: | 39kD |
| GeneID: | 84068 |
| Human Swiss-Prot No: | Q0GE19 |
| Cellular localization: | Cell membrane ; Multi-pass membrane protein . Endoplasmic reticulum membrane ; Multi-pass membrane protein . Golgi apparatus membrane . |
| Background: | similarity:Belongs to the sodium:bile acid symporter family., |